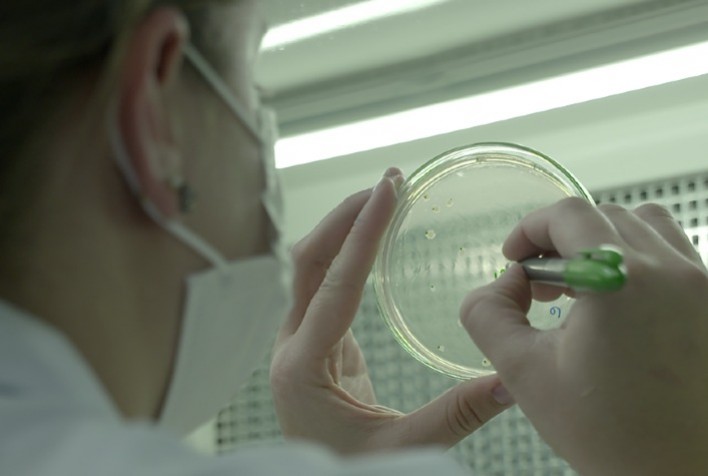
Fundo soberano de Cingapura é o mais novo investidor da Biotrop

Fundo soberano de Cingapura é o mais novo investidor da Biotrop
Com esta operação, empresa brasileira passa a ter um parceiro de renome e conexões globais, que viabilizará a expansão internacional, acelerando o objetivo da companhia em ser líder no mercado de insumos biológicos e naturais nas Américas
Publicado em: 28/07/2021 às 07:40hs
A Biotrop, empresa brasileira especializada em soluções em tecnologia biológica, acaba de anunciar mais uma nova parceria. O Fundo soberano de Cingapura (GIC) entra agora como acionista minoritário relevante dentro da companhia. Com esta operação, a Biotrop ganha um investidor de renome e conexões globais, que viabilizará sua expansão internacional e trará visibilidade global ao Grupo, vital para o alcance do seu objetivo de liderar o mercado de insumos biológicos e naturais nas Américas.
A empresa manterá o controle acionário e a governança de alto padrão. Com o novo sócio, contará com uma estrutura de capital ainda mais sólida para entregar crescimento acelerado nos próximos anos, gerando valor e alto retorno aos seus clientes. “Contar com um investidor do calibre do GIC destaca o valor e o potencial de nosso crescimento e reconhece o trabalho árduo e contínuo de nossa equipe", destaca Antonio Carlos Zem, CEO da Biotrop.O acordo representa a consolidação da marca no setor de biológicos, intensificando seus investimentos no que os tornaram referência nos últimos anos: pesquisa e desenvolvimento de novas tecnologias, aumento da produção e reforços no acesso ao mercado. “Atender nossos clientes com soluções inovadoras e sustentáveis continua sendo nossa maior prioridade”, acrescentou Zem.
Mais sobre a Biotrop
Biotrop é uma empresa focada no desenvolvimento e na produção de insumos agrícolas biológicos de alta tecnologia, uma vertical para promover a sustentabilidade e aumentar a produtividade no agronegócio. Fundada em 2018, com investimentos do Grupo Aqua Capital, consolidou como líder de alto crescimento no mercado brasileiro após a aquisição transformacional da Total Biotecnologia para acelerar seu desenvolvimento. Desde então, cresce organicamente mais de 35% ao ano tanto em receita quanto em Ebitda.
Em 2020, a empresa avançou fortemente na estruturação de bases para o crescimento de longo prazo, acelerando seu programa de P&D e otimizando ainda mais sua produção industrial, S&OP (Planejamento de Vendas e Operações) e estrutura comercial.
A conclusão final da transação com o GIC ainda está sujeita à aprovação do CADE e deve ocorrer em até 60 dias.
Fonte: RuralPress
◄ Leia outras notícias